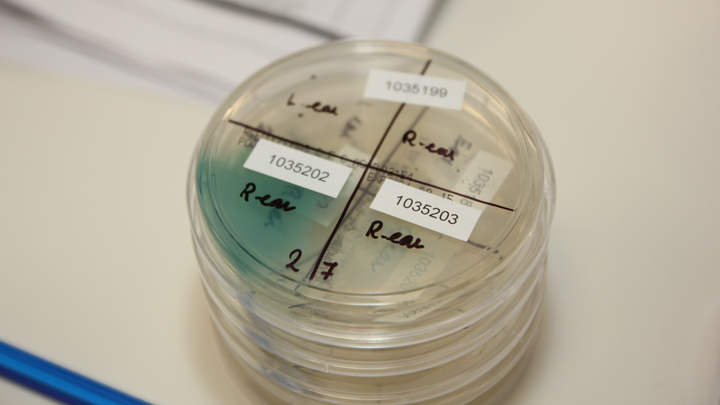
microbiology-3.jpg
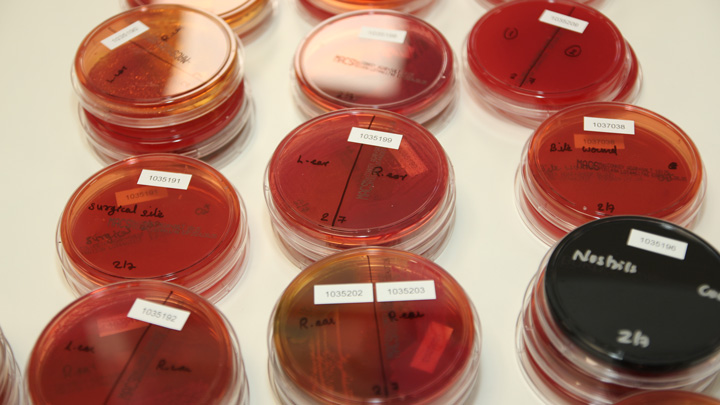
microbiology-1.jpg

Medivet Labs
Our diagnostic laboratory service
Medivet Labs is dedicated to providing a quality diagnostic laboratory service to the veterinary profession using modern technology combined with professional excellence and personal care.

Quality Assured
In 2019, Medivet Labs gained UKAS accreditation to BS EN ISO/IEC 17025:2017.
We are proud to retain this accreditation today - you can view our latest accreditation schedule here.
Accreditation as a testing laboratory confirms our technical competence and is proof of our desire to constantly improve the quality and reliability of our service.
Our services
Our highly qualified staff have access to the latest instrumentation and provide the following services:
Haematology
Five-part leukocyte differential, blood smear evaluation of every sample, and blood coagulation analysis.
Biochemistry
Clinical biochemistry of body systems, endocrinology, drug monitoring, and serology.
Microbiology
Bacterial and fungal culture, mic testing, parasitology, comprehensive urine testing, and PCR screening of infectious agents.
Cytology
Examination of FNAs and fluid cytospin preparations.
Molecular Biology
Our Molecular Biology Team uses sensitive and specific real-time PCR technology to detect infectious organisms in clinical specimen.
Our departments
Cytology
Our team of clinical pathology specialists are experienced in the examination of a wide range of cytology specimens across a number of animal species.
- Cytology submissions are stained using a modified Wright's stain. This gives excellent quality staining for detailed morphological evaluations.
- Cytocentrifuge preparations of fluid specimen submissions (effusions, CSF, washes, synovial fluid, and urine) allow concentration of cells in poorly cellular fluids, for superior morphological assessment.
- Additional measurements for fluid specimens such as manual or automated total nucleated cell counts, total protein or microprotein concentrations, cholesterol and triglycerides, or other biochemical analyte concentrations, are also reported as necessary.
Our clinical pathologists are always happy to discuss their findings further via telephone consultation.

Haematology
The Haematology Team carries out complete blood counts (CBCs), blood smear examinations by microscopy, and coagulation analysis.
- CBCs are generated using our new Sysmex XN1000Vanalyser which uses techniques such as impedance and a variety of flow cytometry methods to reliably differentiate between each cell type, including a 5-part differential leukocyte count.
- Blood smears are made for every whole blood specimen submitted in EDTA. Smears are stained using a modified Wright's stain before being examined by a fully trained Veterinary Biomedical Scientist specialising in Haematology.
- Coagulation analysis is performed on the Sysmex CA660 coagulation analyser which is highly sensitive for testing PT, aPTT & fibrinogen.
- Microscopy is used to screen urine sediment for epithelial and inflammatory cells, bacteria and fungi, crystals and casts.
Other tests carried out by the Haematology Team include canine blood grouping, canine Coombe’s test and in-saline agglutination test.

Biochemistry
The Biochemistry Team is responsible for the quantitative analysis of fundamental chemical analytes.
- A comprehensive chemistry panel can be provided using the Beckman Coulter AU680 or DxC 700 AU in combination with appropriate use of reagents, calibrators and quality control.
- Specialist chemiluminescent immunoassays are performed using the Siemens Immulite 2000 XPI for in vitro concentrations of several endocrinological analytes.
- Within Biochemistry, canine and feline vaccination status’ can be determined using solid phase immunoassays. Other serological immunoassays available include screening tests for FIV, FeLV and Angiostrongylus vasorum.
Microbiology
The Microbiology Team is focused on identifying microbes within a variety of materials.
- In bacteriology, specimens are spread onto relevant agar plates and examined for bacterial growth. Bacterial cultures can be performed on most fluids and sites including urine, faeces, surface swabs and bronchoalveolar lavages (BAL).
- Bacterial identification is carried out using the Vitek 2 XL analyser; traditional techniques such as Gram staining and oxidase testing are also used.
- Antimicrobial susceptibility testing can be carried out using the Vitek 2 XL analyser to generate minimum inhibitory concentration (MIC) values, and/or disc-diffusion.
- Skin scrapes and hair plucks can assist in the diagnosis of skin bacterial, fungal and parasitic infections, using microscopy and culture techniques.
- Faeces can be examined for evidence of protozoan or helminth parasites using the faecal floatation method and/or rapid immunoassays.

Molecular Biology
Our Molecular Biology Team uses sensitive and specific real-time PCR technology to detect infectious organisms in clinical specimens.
- The Molecular Biology Team is responsible for facilitating fast and specific diagnosis of animal diseases by providing start-of-the-art quantitative polymerase chain reaction (qPCR), reverse transcription quantitative PCR (RT-qPCR) and Sanger sequence analysis for species/variant determination to veterinary hospitals and practices.
- We perform quick molecular detection and characterisation of pathogens and provide clinically relevant information to clinicians as soon as possible which allows precise decision-making and target measures such as prophylaxis, appropriate therapy, and biosafety plans to control disease outbreaks.
- Molecular work on a wide range of clinical samples within our laboratory is carried out using KingFisher Nucleic Acid Extraction System and ABI 7500 FAST Real-Time PCR System according to specific and Standard Operating Procedures (SOPs), which have been developed for all our activities.
Please click here to see full range of molecular tests offered by Lab Services Molecular Department.
Our team
-

Chris Hunter, Laboratory Director
Chris has over 25 years of experience in laboratories across various sectors, holds a BSc in Analytical Chemistry and an MBA, and joined Medivet Labs in 2023 after years in the veterinary industry.
-

Laura Snowdon, Laboratory Manager
Laura joined Medivet Labs in 2022 as Laboratory Manager, Laura has a varied background combined of Veterinary Nursing, Human Resources, and Standards Compliance within the Veterinary sector.
-

Robert Mihai Lukacs, Head of Clinical Pathology
Qualifying as a veterinary nurse in Romania, Robert later became a veterinary surgeon at the University of Bologna in 2010. After earning a PhD in 2014, he became a Diplomate in Clinical Pathology in 2021, focusing on cytology, haematology, oncology, and infectious diseases.
-

Sonia Sanchez Redondo, Specialist in Clinical Pathology
Sonia graduated from the University of Leon in 2013. She moved to the UK, worked in small animal practice, completed internships, and earned a postgraduate certificate and a master's degree. She is a Diplomate of the American College of Veterinary Pathologists.
-

Elpida Sarvani, Specialist in Clinical Pathology
Elpida graduated from the Faculty of Veterinary Medicine in Thessaloniki, Greece, and worked as a small animal vet in the UK for six years. She completed a Clinical Pathology residency at the University of Bristol and joined Medivet Labs, contributing to training and support. She is a Diplomate of the American College of Veterinary Pathologists (Clinical Pathology) and of the European College of Clinical Pathologists.
Contact Us
If you would like to contact us, see our contact details below.
Opening hours
Monday - Friday 9am - 5pm
Saturday 9am - 12pm
Sunday and Bank Holidays Closed
Contact details
T: 01923 252 800
E: medivet.labs@medivet.co.uk
Find us
Medivet Labs
Unit 8
Mowat Industrial Estate
Watford
Hertfordshire
WD24 7UY

